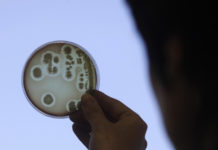

Специалисты трансформировали моно-звук в формат 2,5D
Сегодня талантливая команда специалистов из Техасского Университета в Остине совместно со своими коллегами по программному инжинирингу из Facebook представила свою нов...
Разработка Essential Phone окончательно прекращена
Еще в 2017 году, достаточно интересный и многообещающий стартап Essential, главой которого стал один из разработчиков операционной системы Android, Энди Рубин, предлож...
Представлен уникальный робот с волнистыми плавниками Velox
На протяжении последних нескольких лет мы могла наблюдать за развитием и воплощением множества интересных видов робототехнического дизайна – от самых мелких до самых н...
Электростимуляция нового отдела мозга позволяет бороться с депрессией
Новое исследование специалистов из Калифорнийского Университета в отношении изучения нового региона мозга под названием орбитофронтальной коры, продемонстрировало, что...
Федеральная торговая комиссия заинтересовалась антиконкурентной политикой Amazon
Буквально вчера поступила информация о том, что коалиция, состоящая из некоторого числа крупнейших профсоюзов на территории Соединённых Штатов Америки, официально обрат...
Apple собирается выпустить для iPad клавиатуру с трекпадом
Если верить информации, которая на днях была опубликована на страницах авторитетного издания The Information, корпорация Apple планирует уже совсем скоро выпустить свою...
Представлен бюджетный биосенсор инфекций
Диагностика различных видов инфекций и инфекционных заболеваний представляет собой обычно достаточно длительный процесс – так как на получение и проверку результатов о...
Синтетические молекулы помогут победить склероз
В случае множественного склероза, иммунная система человека действует таким образом, что своими усилиями уничтожает миелин, являющийся инсулированным слоем на конце не...
Ученые установили некоторые подробности «присасывания» бактерии к ДНК
Бактерии развиваются достаточно быстро – в частности, приобретая известную степень устойчивости против антибиотиков, нацеленных на их уничтожение. Именно этот фактор п...
Наша возможность долго бегать обязана своему появлению генной мутации
Около двух-трех миллионов лет тому назад наши предки-гоминиды начали испытывать серьезные изменения в контексте своего генома – что в дальнейшем выразилось в формирова...